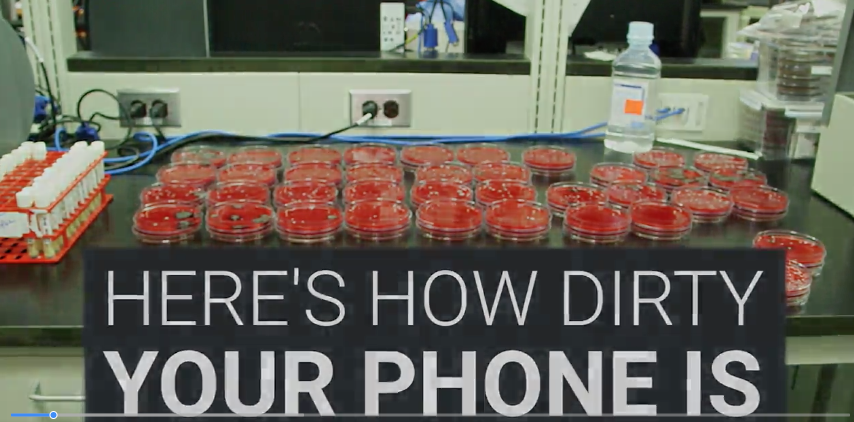
Germs, bacteria, and diseases living on your phone

¿Bacterias resistentes a los antibióticos? ¡El demonio de Tasmania al rescate!
Hablemos Claro El desarrollo y la lactancia del demonio de Tasmania podrían ser la clave para tener antibióticos naturales contra bacterias que se han hecho resistentes a esas medicinas. El demonio de Tasmania puede representar más que los recuerdos de alguna caricatura que vimos en la infancia, ya que la leche materna de esta especie […]
Energy balance explained – get the balance right!
This video explains the science behind energy balance and how it affects you. It provides practical tips – small steps that you can incorporate in your lifestyle to reach a healthy balance! Explore your energy balance on http://www.eufic.org/page/en/page/ene…. For EUFIC online updates subscribe onhttp://www.eufic.org/page/en/page/SUB…
What is the Heisenberg Uncertainty Principle? – Chad Orzel
The Heisenberg Uncertainty Principle states that you can never simultaneously know the exact position and the exact speed of an object. Why not? Because everything in the universe behaves like both a particle and a wave at the same time. Chad Orzel navigates this complex concept of quantum physics.
El estatus social de los macacos influye en su sistema inmune
Agencia SINC En las sociedades humanas, las diferencias entre pobres y ricos se reflejan en parte en la esperanza de vida, que puede variar en 10 años entre unos y otros. Hasta ahora, se pensaba que las desigualdades socioeconómicas generadas repercuten en la salud porque las personas con menos recursos tienen menor atención sanitaria y […]
Tu perro recuerda lo que hiciste
Agencia SINC Las personas tenemos una increíble habilidad para recordar cosas del pasado, incluso cuando es algo de poca o nula importancia. Evocar lo que cenamos en las navidades pasadas o aquel chiste que contó un amigo hace tres meses forma parte de los procesos de la memoria episódica. Un estudio publicado en Current Biology, […]
Tiro de escopeta. MIGUEL F. MARTÍNEZ
Por Ismael Vidales Delgado Miguel F. Martínez es el primer BENEMÉRITO DE LA EDUCACIÓN en Nuevo León, por Decreto No. 56 de la XXXVII Legislatura, publicado en el Periódico Oficial el día 20 de mayo de 1918 siendo gobernador del Estado don Nicéforo Zambrano. Hay varias biografías suyas, pero la mejor es la que él […]
Portales de la imaginación
Gabriel Contreras Los dados son portales de la imaginación. Y no hablo de magia, hablo de creatividad. Por mi experiencia al frente de grupos de creación artística y de creatividad en general, puedo asentar que los dados son una herramienta importantísima en lo correspondiente al desarrollo de la inteligencia creativa, el manejo del azar y […]
Germs, bacteria, and diseases living on your phone
Many of us take our phones with us wherever we go, including the bathroom. We were curious how this affected the phones, and if there could be any bacteria, pathogens, or anything else on them.
Earth is getting greener
https://svs.gsfc.nasa.gov/vis/a010000/a012200/a012226/12222-1920viz-MASTER_high.mp4 NASA Más información: https://svs.gsfc.nasa.gov/cgi-bin/details.cgi?aid=12226
¿Qué mecanismos cerebrales explican la falta de sensibilidad a la música?
IDIBELL Científicos del grupo de Cognición y Plasticidad Cerebral del Instituto de Investigación Biomédica de Bellvitge y de la Universidad de Barcelona (IDIBELL-UB), en colaboración con la Universidad de McGill (Montreal), han publicado un nuevo estudio en el que determinan los mecanismos cerebrales que explican la falta de sensibilidad a la música. A pesar de […]
La nueva emergencia médica se llama cambio climático
Adeline Marcos | Marrakech Cuando hablamos de muertes asociadas al aumento de la temperatura, a la mente nos vienen imágenes de desastres naturales, sequías e inundaciones devastadoras en zonas del mundo más empobrecidas. Pero los efectos del cambio climático en la salud son universales. Además de los efectos directos como inundaciones, tormentas, sequías y clima […]
¿Esto es real?
Rodrigo Soto Moreno Si la memoria no me falla, fue caminando en el patio de piedras de casa de mi bisabuela Ena y de mi bisabuelo Félix, con apenas 5 años en el planeta Tierra, cuando experimenté la sensación de estar consciente, del denominado “pienso, luego existo” de René Descartes, del sentir que mi mente […]
Noviembre en la historia de la UANL
Jorge Pedraza Salinas Importantes acontecimientos se desarrollan en el mes de noviembre en la UANL. Está, por ejemplo, la creación del Colegio Civil del Estado, de la Ciudad Universitaria, de la Biblioteca Universitaria Capilla Alfonsina y de la Biblioteca Magna Raúl Rangel Frías. También en noviembre un Rector de la UANL es designado Secretario de […]
De carne y hueso: GANDHI MY FATHER
Por Ismael Vidales Delgado Leí hace tiempo en un diario internacional, el encabezado siguiente “Gandhi, padre de la nación y un extraño para su hijo.” Esta inusual declaración entre la inmensidad de textos favorables a tan emblemático personaje, provocó mi curiosidad y me di a la tarea de investigar a qué se refería esta lapidaria […]